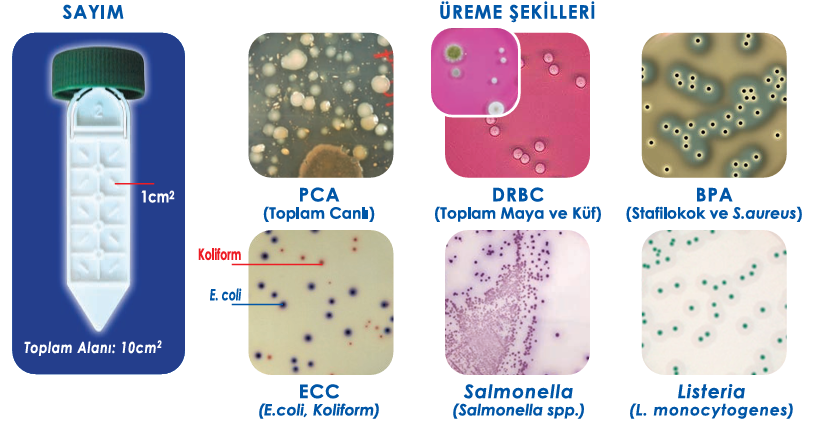

Hytech Slide Hijyen Kontrol Kitleri Nedir? Nerelerde Kullanılır?
Hytech Slide Hijyen Kontrol Kitleri Nedir? Nerelerde Kullanılır?
Hijyen kontrolü, özellikle üretim yapılan alanlarda kalite güvence süreçlerinin en kritik aşamalarından biridir. Hytech Slide Hijyen Kontrol Kitleri, yüzey, personel, sıvı ve katı numunelerde hızlı mikrobiyolojik analiz yapmayı mümkün kılan pratik bir test yöntemidir.
Klasik swab yöntemine göre daha yüksek mikroorganizma toplama oranına sahiptir ve analiz sürecini önemli ölçüde hızlandırır.
Hytech Slide Nasıl Çalışır?
Hytech Slide üzerinde iki farklı besiyeri bulunur. Bu yapı sayesinde tek bir test ile iki mikrobiyal analiz yapılabilir. Slayt yüzeye hafifçe bastırılarak uygulanır veya sıvı örneklerde kısa bir daldırma işlemi yapılır. Ardından inkübasyona alınarak sonuçlar gözlemlenir.
İnkübasyon Süreleri:
Analiz Türü | Sıcaklık | Süre |
Bakteri Analizi | 37 °C | 24–48 saat |
Küf ve Maya | 25 °C | 72–120 saat |
İnkübatör yoksa oda sıcaklığında yaklaşık 5 gün içinde sonuç görülebilir.
Hytech Slide ile Klasik Swab Yöntemi Arasındaki Fark
- Daha yüksek mikroorganizma kazanım oranı
- Tek adımda ekim + toplama işlemi
- Maliyet avantajı
- Daha hızlı sonuç alma
Bu avantajlar, Hytech Slide’ı üretim alanlarında tercih edilen en pratik hijyen kontrol yöntemlerinden biri haline getirir.

Kullanım Alanları
Hytech Slide aşağıdaki alanlarda yaygın olarak kullanılmaktadır:
- Gıda ve içecek üretimi
- Su analiz laboratuvarları
- İlaç ve medikal üretim tesisleri
- Kozmetik ve kişisel bakım ürünleri üretimi
- Hastaneler ve steril alan kontrolü
- Hayvancılık ve yem tesisleri
- Okullar, oteller, toplu yaşam alanları

Hangi Modeller Mevcuttur?
Aşağıdaki Hytech Slide çeşitleri mikrobiyolojik parametrelere göre seçilir:
- VRBG/ECC: Enterobacteriaceae ve E.coli/Coliform grubu bakterilerin hızlı ve seçici olarak tespitinde kullanılır. Özellikle gıda ve çevresel hijyen kontrollerinde tercih edilir.
- PCA/ECC: Toplam aerob mezofilik bakteri sayımı ile birlikte E.coli/Coliform analizi yapılmasını sağlar. Çift amaçlı hijyen izleme çalışmaları için idealdir.
- DRBC/ECC: Küf ve maya kontaminasyonu ile birlikte E.coli/Coliform tespiti için kullanılır. Üretim hatları, yüzeyler ve gıda sektöründe yaygındır.
- BPA/ECC: Personel el hijyeni ve temas yüzeyi kontrolleri için geliştirilmiştir. Hem toplam bakteri hem de E.coli/Coliform analizlerini destekler.
- PCA/DRBC: Bir tarafında toplam bakteri, diğer yüzünde ise maya ve küf gelişimini değerlendirin. Üretim ortamı hijyeni için çok yönlü bir çözümdür.
- Toplam Canlı: Genel bakteriyel yük tespiti için kullanılır ve hijyen validasyonu, temizlik sonrası kontrol ve rutin kalite güvence analizlerinde kullanılır.
- Küf - Maya: Özellikle maya ve küf kontaminasyonunun izlenmesi gereken içecek, gıda, kozmetik ve ortam hijyen testlerinde kullanılır.
- E. coli / Coliform: Fekal kaynaklı kontaminasyonun tespiti için geliştirilmiştir ve hızlı sonuç sağlar.
- Kombinasyon Setleri: Belirli analiz hedeflerine göre seçilmiş çift taraflı besiyerleri ile kapsamlı hijyen kontrolünü tek kitte sağlar.
Bu çeşitlilik, her uygulama için doğru besiyerinin seçilebilmesini sağlar.

Hytech Slide Hijyen Kontrol Kitleri, hızlı, ekonomik ve güvenilir mikrobiyolojik test yöntemi sunar. Gıda güvenliği, üretim hijyeni ve kalite kontrol süreçlerinde doğru kullanım ile kontaminasyon kaynaklarının belirlenmesini kolaylaştırır ve riskleri en aza indirir.
Hijyen kontrol kitleri için detaylı bilgi almak isterseniz Sentezlab'a her zaman ulaşabilirsiniz.